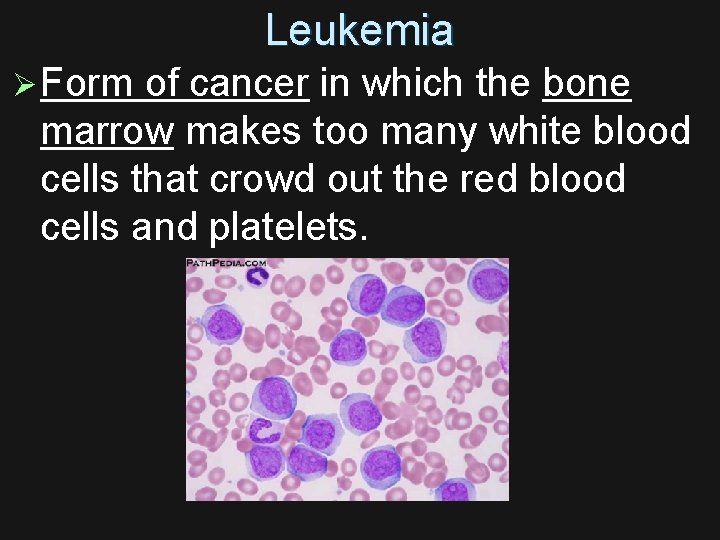
Leukemia Ø Form of cancer in which the bone marrow makes too many white

Body Systems Unit Digestive System Circulatory System Respiratory

Body Systems Unit: Digestive System Circulatory System Respiratory System Excretory System

The Digestive System

SALIVARY GLAND EPIGLOTTIS MOUTH TONGUE ESOPHAGUS LIVER GALL BLADDER STOMACH PANCREAS LARGE INTESTINE SMALL INTESTINE APPENDIX PANCREAS ANUS RECTUM



A: What is the function of the digestive system? Ø To break down food into molecules small enough to fit through the cell membrane.

A: What is the function of the digestive system? Ø The digested food gets carried to every cell to provide glucose for respiration and other material to build new cells.

B: What path does food take as it travels through the body? 1. 2. 3. 4. 5. 6. 7. Mouth Epiglottis Esophagus Stomach Small intestine Large intestine Rectum/Anus

*** C: Food never goes into the liver, gall bladder, or pancreas!! These organs make chemicals that break down food.

D: Two Types of Digestion Ø Mechanical Digestion: physically break large pieces of food into smaller pieces. (Increases surface area for chemical digestion) Ø Example: Teeth and stomach muscles churning

D: Two Types of Digestion Ø Chemical Digestion: enzymes breaking down large molecules into smaller ones. Ø Ex: starch glucose Ø Ex: protein amino acids

Epiglottis Ø A flap of skin that covers your wind pipe so you don’t choke when you swallow.

Esophagus Ø Food moves by peristalsis Ø Peristalsis: Muscle contractions along the digestive tract that move food and waste along.

Stomach contracted when empty

E. Stomach Ø Contains gastric juices: made up of mucus, pepsin, and hydrochloric acid Ø Both mechanical and chemical digestion occur here. Ø Pepsin: an enzyme (chemical) that breaks down protein

Inside the stomach

F. Small Intestine Ø The most important organ for digestion. Ø Organ where most digestion occurs. Ø Where digestion is completed.

Duodenum

5. Small Intestine Ø Enzymes aid in the final digestion of proteins, carbohydrates, and lipids. Ø ACCESSORY ORGANS: The liver, pancreas, and gall bladder pump enzymes into the small intestine to help digest food.

Ø Liver: makes bile which is stored in the gall bladder. Bile is a green liquid that breaks down fats.

Ø Pancreas: Pumps pancreatic juices into the small intestine that break down proteins, starches, and fats. Also releases bicarbonate to neutralize stomach acid

Ø Villi are fingerlike projections that line the small intestine to increase surface area for absorption of nutrients. Ø Each villi is surrounded by capillaries to absorb nutrients so that the blood can take the digested food to the cells of the body.

Villi

Section of a small intestine See the villi? Increase surface area to absorb more nutrients from the digested food!. Why so red? ? Lots of capillaries surrounding it!

Small intestine is 23 ft long Large intestine is 5 ft long…its called large because its very wide

G. Large Intestine Ø Water and minerals are absorbed in the large intestines Ø Helpful bacteria feed off the passing materials and make vitamins K and B

Appendix



H: Digestive Disorders Ø Constipation: Too much water is absorbed by the large intestine. Ø Solution? Ø Eat more fiber and drink more water.

H: Digestive Disorders Ø Diarrhea: Too little water is absorbed by the large intestine.

Ø Heartburn: Stomach acid came up out of stomach causing a burning sensation in esophagus Ø Solution? Ø Antacids or change in diet if it occurs often.

Ø Ulcers: open sores that develop on the Ulcers: inside lining of your esophagus, stomach and the upper portion of your small intestine. Ø Solution: See the doctor

Ø Wha Endoscope

Intestinal Endoscopy

Polyp removal

Ø Gall stones: small stones from crystallized bile Gall stones: usually found in the gall bladder that block the bile duct. (Bile is secreted by the liver and stalled in the gall bladder where it removes water to make the bile more concentrated. ) Ø Solution: See the doctor – may have you change diet, medicine, or have surgery to remove it.

The Circulatory System

The function of the circulatory system: Ø To deliver food and oxygen to body cells and carries carbon dioxide and other waste products away from the body cells

Ø Transport Systems Ø Materials are transported around the body by either blood or lymph. Ø What is in blood? Ø Plasma Ø Platelets Ø Red Blood Cells Ø White Blood Cells


Components of blood Plasma: Ø The liquid part of blood. Ø Made up of water, dissolved salts, nutrients, gases, and molecular wastes, hormones. Ø Plasma holds the rest of the materials in blood.

Platelets ØContain chemicals to clot blood.

Red Blood Cells Ø Contain hemoglobin which transports oxygen. Ø Made in bone marrow.

Red Blood Cells Ø Most abundant Ø Round with thick ends and thin center Ø No nuclei Ø Hemoglobin – binds oxygen to it so it can go to cells in the body Ø Made in bone marrow Ø Lives 120 days Ø Destroyed in the spleen


White Blood Cells Ø White blood cells: Fight infection Ø There are different types: Ø Phagocytes: Engulf and destroy bacteria that enter bloodstream through breaks in the skin surface. Ø Lymphocytes: Produce antibodies that recognize and attack antigens that invade the body.

Blood Types 6: 02

Intro to Circulation 1: 10

Arteries Ø Carry blood away from the heart to the body. Ø Carry blood high in oxygen. Ø Largest artery is called the aorta. Ø Blood is under pressure in the arteries. When you take your pulse you are feeling the contraction of arteries.

Veins Ø Carry blood towards the heart from the body. Ø Have one-way valves that prevent the backwards flow of blood. Ø Carry blood high in carbon dioxide.

Capillaries Ø Only one cell thick. Connect arteries to veins. Ø All materials exchanged with cells is done by the capillaries. (diffusion) Ø Dissolved materials are exchanged by diffusion through the thin walls of the capillaries. Ø Red blood cells travel single file

1. The smallest blood vessels are the Ø capillaries. 2. The blood vessel under the highest pressure is the Ø artery. 3. In our bodies we have more Ø capillaries than any other blood vessel.

Blood vessel video clip 1 min

High Blood Pressure Ø Damages lining of arteries and weakens heart muscle. Ø Caused by stress, diet, smoking, aging, and heredity. Ø Another name for high blood pressure is hypertension.
Leukemia Ø Form of cancer in which the bone marrow makes too many white blood cells that crowd out the red blood cells and platelets.

Anemia Ø The blood does not have enough hemoglobin or red blood cells causing the cells to not get enough oxygen. Ø Anemia is caused by not enough iron in your diet. Ø Anemia makes you feel very tired all the time.

Coronary Thrombosis ( common cause of Heart Attack) Ø Coronary arteries or its branches are blocked and some muscle tissue of the heart is deprived of oxygen and is damaged.

Sickle Cell Anemia Ø Red blood cells are not their normal shape and this can cause blockage of blood vessels. Ø It is caused by heredity.

The four parts of blood What does it do?

2. Describe the two differences between arteries and veins. 1. 2. 3. In which type of blood vessel does the transfer of materials between the cells and the blood take place? ______________ 4. Look at the diagram on the first page of the circulatory system notes. What is your blood mostly made up of? ________ 5. What is the second most thing your blood is made up of? ___________ 6. Why is it important that your blood is made up of so much of this? ________________________

Amazing Heart Facts • Put your hand on your heart. Did you place your hand on the left side of your chest? Many people do, but the heart is actually located almost in the center of the chest, between the lungs. It's tipped slightly so that a part of it sticks out and taps against the left side of the chest, which is what makes it seem as though it is located there. • Hold out your hand make a fist. If you're a kid, your heart is about the same size as your fist, and if you're an adult, it's about the same size as two fists

. The aorta, the largest artery in the body, is almost the diameter of a garden hose. Capillaries, on the other hand, are so small that it takes ten of them to equal the thickness of a human hair. . Your body has about 5. 6 liters (6 quarts) of blood. This 5. 6 liters of blood circulates through the body three times every minute. In one day, the blood travels a total of 19, 000 km (12, 000 miles)—that's four times the distance across the US from coast to coast. . The heart pumps about 1 million barrels of blood during an average lifetime—that's enough to fill more than 3 super tankers.

. Your heart beats about 100, 000 times in one day and about 35 million times in a year. During an average lifetime, the human heart will beat more than 2. 5 billion times. . Give a tennis ball a good, hard squeeze. You're using about the same amount of force your heart uses to pump blood out to the body. Even at rest, the muscles of the heart work hard—twice as hard as the leg muscles of a person sprinting. . Feel your pulse by placing two fingers at pulse points on your neck or wrists. The pulse you feel is blood stopping and starting as it moves through your arteries. As a kid, your resting pulse might range from 90 to 120 beats per minute. As an adult, your pulse rate slows to an average of 72 beats per minute.

Flow of blood in the body heart lungs (to pick up OXYGEN and drop off CARBON DIOXIDE) back to the heart travels to all cells in the body back to heart

The Heart 53 s

Flow of blood in the heart 1. 2. 3. 4. 5. 6. Right atrium Right ventricle Lungs (to pick up oxygen and get rid of CO 2 Left atrium Left ventricle All parts of the body

Blood’s Journey 2: 14

Valves Ø a flap of tissue between atrium and ventricles Ø Prevent blood from flowing the wrong way

7. Vena Cava 3 Pulmonary Artery 6 4 1 5 2

The purpose of the Human Respiratory System is to exchange gases (O 2 and CO 2) between the external environment and the bloodstream.

Ø The Pathway of Air Ø Nose & Mouth Pharynx and Larynx Epiglottis Trachea Bronchioles Alveoli → Bloodstream

Diaphragm: Muscle below lungs that assists in breathing

Nose/Nasal Passage: l Air enters here l Warms and humidifies the air l Lined with mucous and cilia to trap dust/debris

Ø Pharynx: The back of the throat Ø Ø Larynx: Vocal cords are located here

Ø Epiglottis: Flap of tissue that prevents food from entering trachea/lungs Ø Trachea: (windpipe) supported by rings of cartilage

Bronchi: Main branches (2) of the trachea that go to the lungs Bronchioles: Smallest air tubes which end at the alveoli or air sacs

Ø Alveoli: FUNCTIONAL UNIT OF THE LUNG Ø The site of respiratory gas exchange Ø They have thin, moist surfaces Ø Each alveolus is surrounded by capillaries Ø O 2 diffuses from the alveoli into the bloodstream Ø CO 2 and H 2 O (end products of cellular respiration) diffuse from the bloodstream into the alveoli




What makes you breath? The Medulla Oblongata in the brain is responsible for your rate of breathing. It monitors the level of CO 2 in the bloodstream. Breathing is an involuntary action – we do not have to think about it! If an increase in CO 2 is detected by the Medulla in the brain, it will automatically send a message to the lungs to increase the rate of breathing. This will let off more CO 2 and decrease the amount in your blood.

Diseases of the Respiratory System Any disease or disorder is a failure to maintain homeostasis.

Asthma – a severe allergic reaction (immune response) that causes breathing difficulties such as wheezing, coughing, shortness of breath. The air passages narrow/spasm.

Bronchitis – an inflammation of the bronchi. The lining becomes swollen and irritated. Increases mucus production. Can be caused by a virus or bacteria.

Emphysema – condition where walls of the alveoli break down. Gas exchange can not occur properly. Lungs develop holes, lose their elasticity, and alveoli become damaged. Causes severe shortness of breath. Smoking is the leading cause of emphysema.

Normal Chest X Ray on Left Emphysema Chest X Ray on Right (black = air)

Pneumonia – Alveoli become filled with fluid, prevents gas exchange.

Lung Cancer – uncontrolled cell growth that may result in tumors. Approximately 80% of all cases of lung cancer are due to cigarette smoking.

Excretion: the elimination of cellular wastes from an organism. We have to get rid of waste from our body or else we will be poisoned by it.

What adaptations do we have for excretion? Lungs: Excretes carbon dioxide and water vapor.

Skin: Ø Contains sweat glands. Ø Excrete water, salt, and urea (made in liver) as perspiration. Ø Regulates body temperature: When perspiration evaporates it carries with it body heat. This cools the body.

Liver: Ø Makes urea. Ø Urea is the nitrogenous waste product of humans. When our body digests protein down into amino acids the extra amino acids our body does not need is further broken down to become urea. Ø Nitrogenous waste comes from protein (CHON)

Kidneys: Ø Filters the blood and removes urea, salts, minerals, and water from the blood stream. Ø The functional unit of the kidney is the nephron.

Ø Regulate the chemical composition of the blood. Things your body needs to function such as sodium or potassium can be returned to the bloodstream from the nephrons. This regulates the chemicals in the blood so that the correct amounts are there to keep you healthy. Ø Where are my kidneys? Ø The kidneys are two bean-shaped organs about the same size as a fist. They are located near the middle of the back, one on either side of the spine.



Ø Ureters: Tubes that carries urine from the kidneys to the bladder. Ø Urinary Bladder: Stores urine until excretion. Ø Urethra: Tube that carries urine from bladder to outside of body

Excretory System Disorders Kidney failure: The kidneys do not filter properly. A patient must have dialysis if this occurs.

Kidney Stones: Collections of solid material that may block the kidneys, ureters, or bladder.

Ø Gout: disease that is very painful due to uric acid crystals in joints. Ø

Ø Cirrhosis of the liver: disease of liver that is caused by damage to the cells. Most common cause is alcoholism.
- Slides: 102